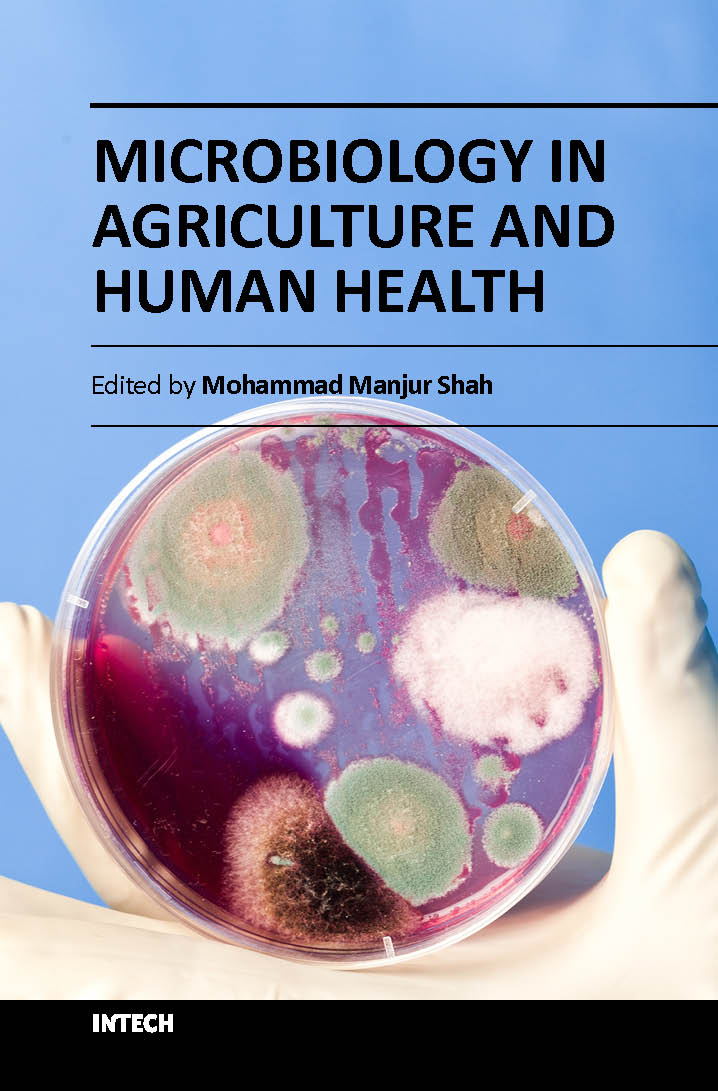
Microbiology in agriculture and human health (hb 2017)

Microbiology involves the study of microscopic living organisms. Most of them are unicellular and all the life processes are performed by a single cell. They are associated with the health and welfare of human beings. Among the biological sciences, microbiology has established itself a place in the current century. Microorganisms also provide experimental models in various research activities, and an answer to numerous fundamental questions in genetics / metabolism, cell form and function. This book is presented in six chapters comprising of two sections. The first section deals with Microbiology and Agriculture and the second section deals with Microbiology and Human Health. The book is expected to attract wide audience from various fields of biological sciences in general, and microbiologists in particular.
| Specifications |
Descriptions |
| ISBN |
9789535121442 |
| Published Year |
2017 |
| Binding |
Hardcover |
| Subject |
Agriculture |
| Pages |
142 |
| Weight |
0.4 (In Kg) |
| Readership |
NA |